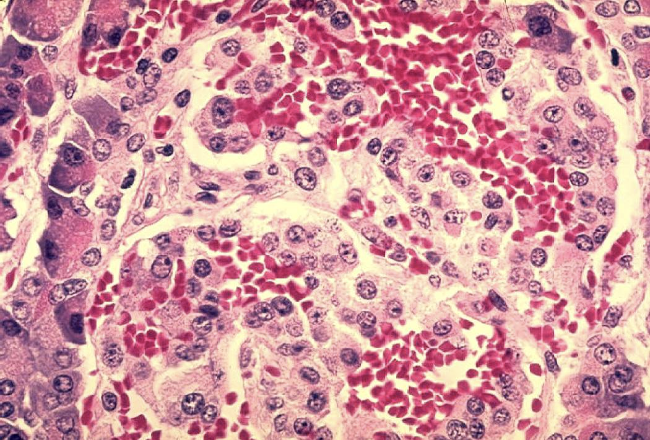

La isla de la abundancia
HAGO Y EXPERIMENTO
Dra Paulina Seguí
1/5/20242 min read
Cuando nos acercamos en el microscopio a ver las células del páncreas se pueden observar varios tipos y el médico que las vió por primera vez dijo que era como una isla en el mar y le puso los islotes de Langerhans (este es el médico que los describió por primer vez) ¿qué opinas? y son entre ¡1 y 2 millones de islotes!

Las hormonas son sustancias que se producen en la glándula y que se transportan por todo el cuerpo realizando diferentes funciones. En este caso se producen glucagón e insulina y las dos sirven para que la célula tenga alimento, algún día te platicaré de cómo cada célula del cuerpo es un organismo por sí misma. El glucagón se produce cuando a la célula le falta glucosa y la insulina se necesita para que esa glucosa se pueda introducir a la célula. Esta glucosa se utiliza como fuente de energía dentro de la célula, entonces todo es un círculo de ayuda mutua entre unos y otros para que todo el cuerpo funcione bien.
Así como Inmu, Mune, Conti y Tire hacen comunidad con los animales y los árboles y los insectos, dentro de nuestro cuerpo cada una de las células que forman a los órganos, hacen comunidad entre ellas y entre todos. Todo está conectado, como el pan = todo (esto es un juego de palabras, son divertidos).
Y las enzimas que hace el páncreas son unas sustancias que ayudan a que en todo el intestino se rompan los alimentos que comemos y se hagan chiquitititititititos para que entonces quede la glucosa solita, la proteína y la grasa y así se vaya a donde se tenga que ir para producir hormonas y enzimas. Te vuelvo a recordar, todo está conectado.






Con esto ya sabes que pasa cada vez que comes y mientras no comes. Cómo es que cada una de las células de nuestro cuerpo se siguen alimentando durante todo el día. Mientras más frutas y verduras comamos, más le ayudamos al páncreas a seguir con sus abundantes islas sanas.
Bibliografía:
Guyton and Hall. Medical Physiology. 14th edition Elsevier 2016

